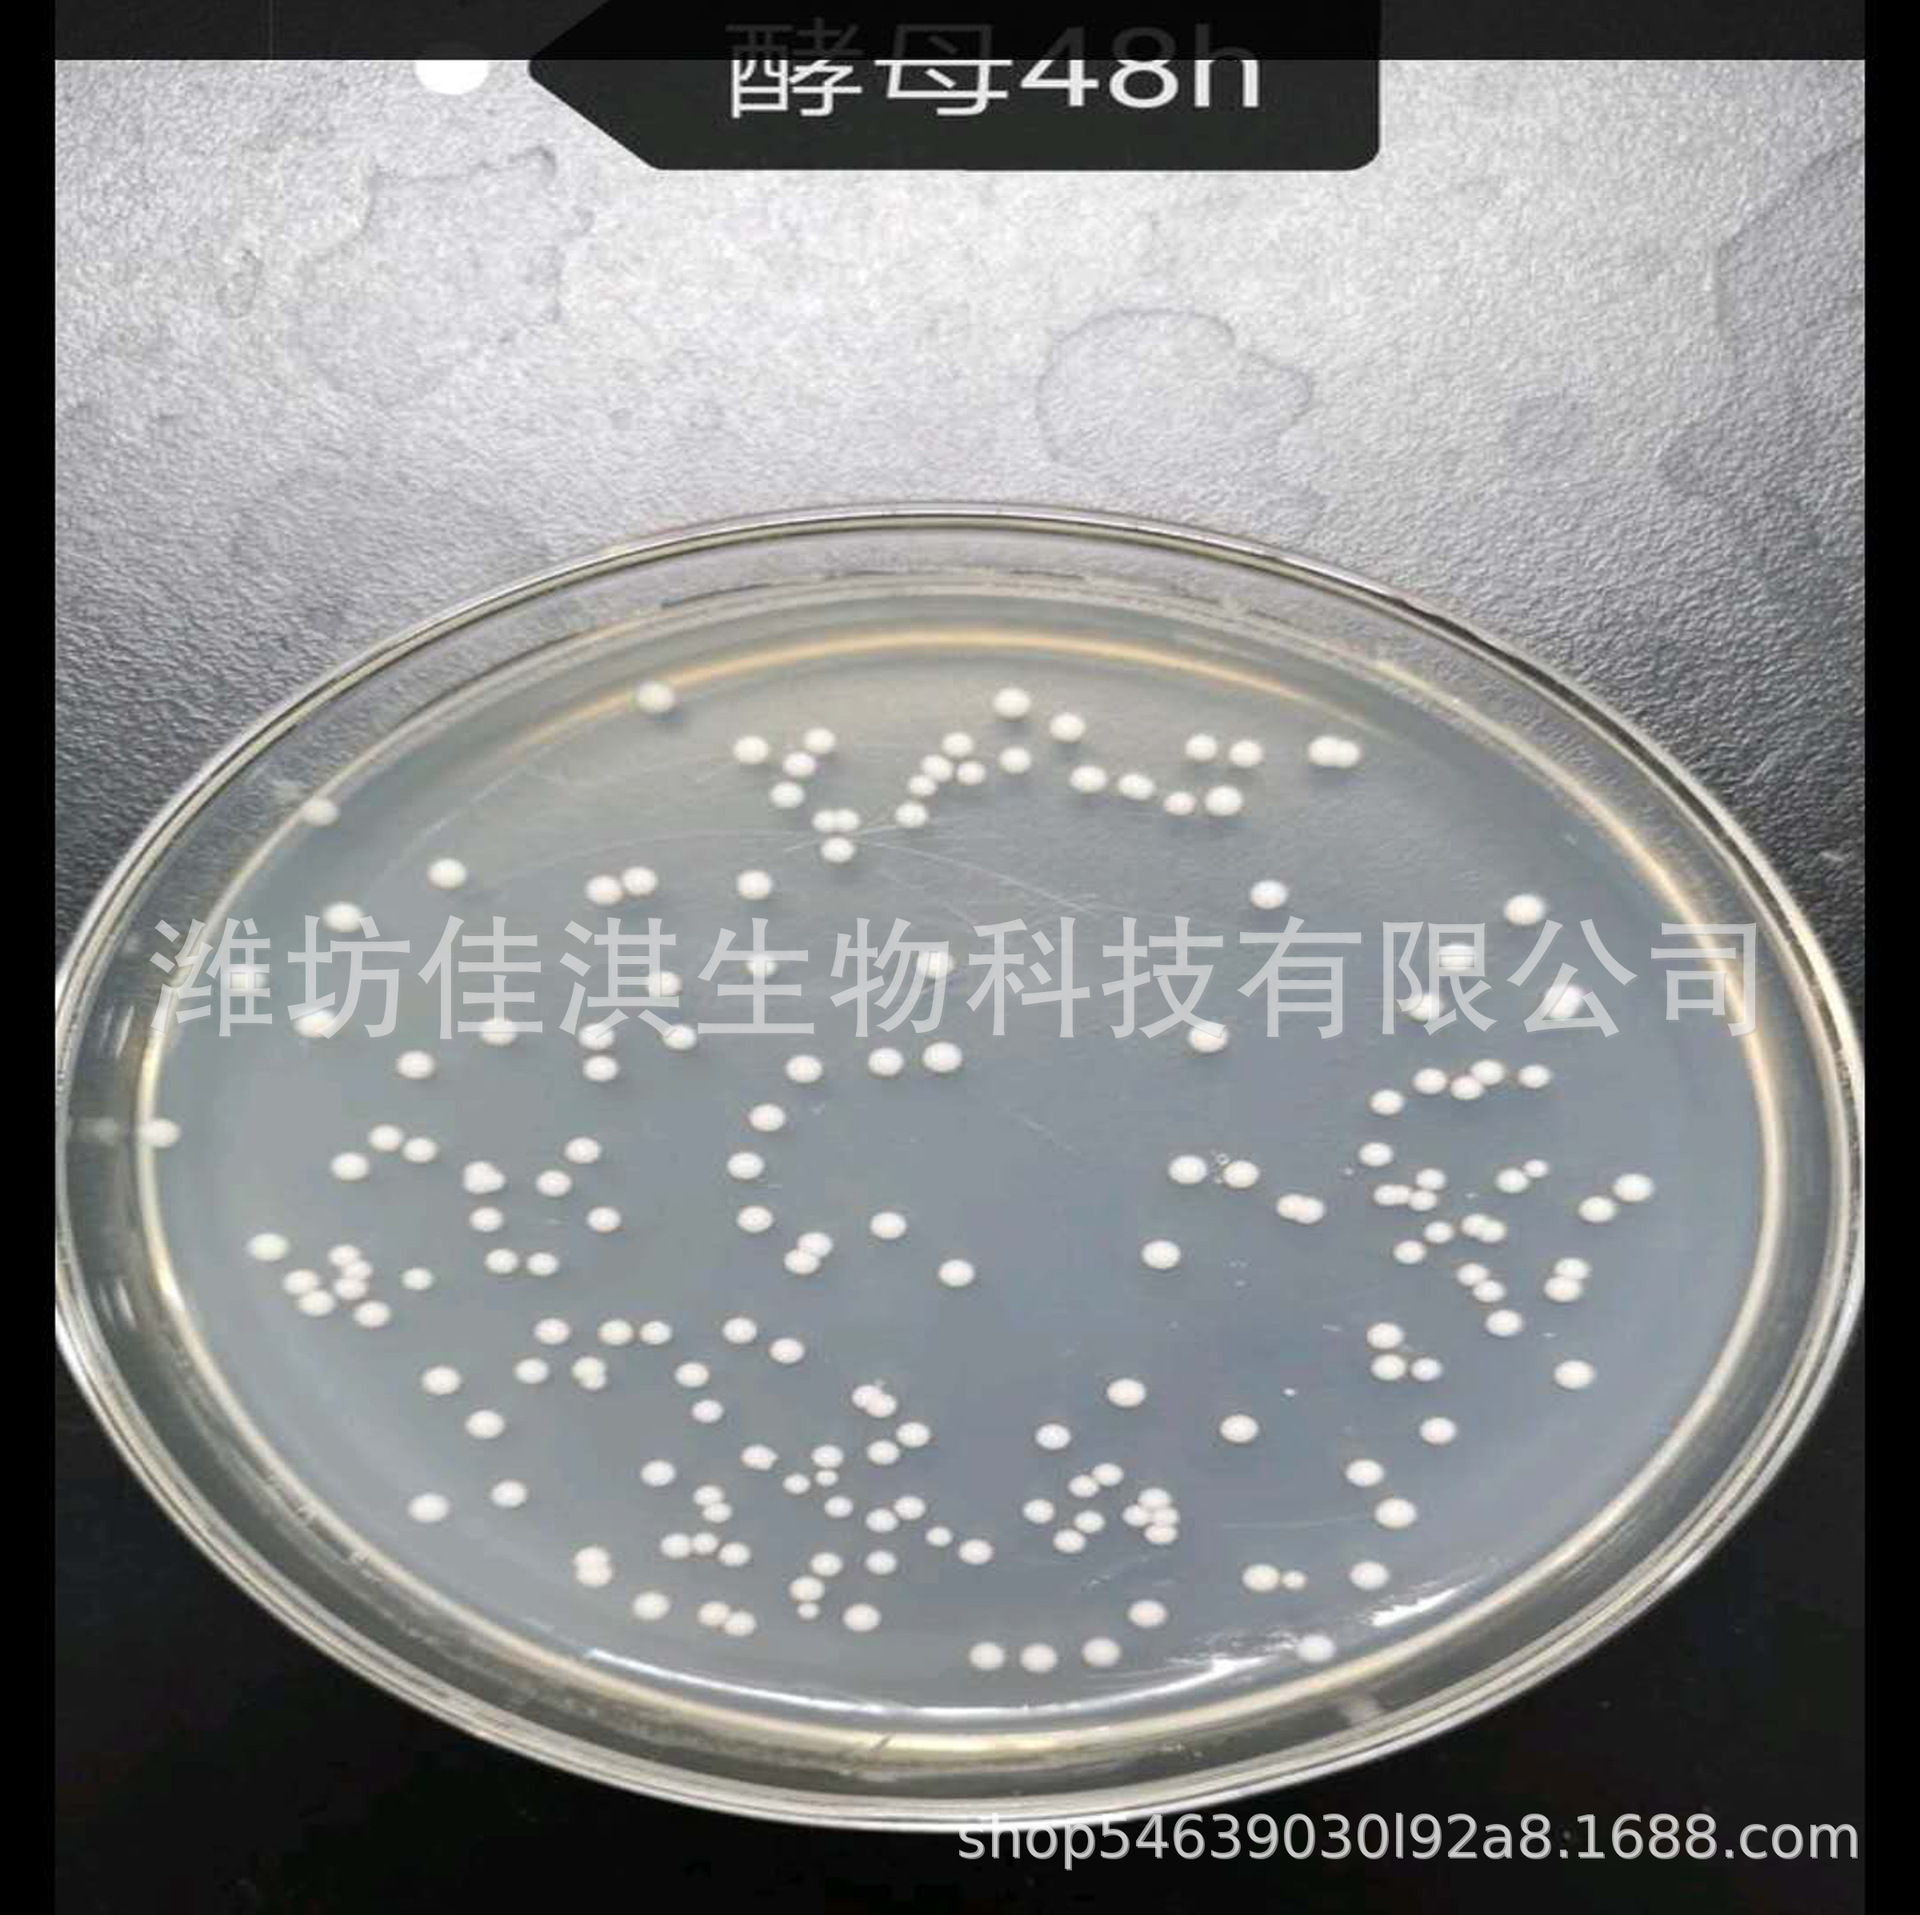

Производители Оптовые морские дрожжи Дрожжи пивные дрожжи кормовые добавки дрожжи
Всего продаж:
999909 шт.
Минимальное количество для заказа:
25 шт.
Производители Оптовые морские дрожжи Дрожжи пивные дрожжи кормовые добавки дрожжи
от 555.50 ₽ за 1 шт.
-21%
555.50 ₽
Доставка по Китаю включена в цену
Оптом
от 25 шт.
555.50 ₽
от 100 шт.
530.81 ₽
Описание
海洋红酵母
【产品性状】: 黄色粉末
【主要成分】:有效总菌数≥1000亿/g、粗蛋白≥35%、虾青素≥600μg/g
【作用功效】:
1、强苗壮体:本品富含类胡萝卜素,能够有效地提高水产动物的免疫力,抗氧化能力;由于海洋红酵母中所含类胡萝卜素是对抗自由基有效的抗氧化剂之一,所以本品具有很强的抗氧化、消除自由基能力,可以促进抗体的产生、增强宿主的免疫功能。
2、营养促长:海洋红酵母含有丰富的菌体蛋白和B族维生素及不饱和脂肪酸,能够弥补常规饵料的营养缺陷,另外海洋红酵母在生长过程中还能够分泌多种高活性的消化酶,产生多种维生素和未知生长因子可以促进饵料的消化吸收,本品可在提高苗种成活率的同时提高饲料效率。
3、降低发病率:按用量投入本品后,海洋红酵母菌可在育苗水体的微生态系统中形成种群优势,抑制其它杂菌和有害菌的生长繁殖,降低发病率,本品富含的营养物质同时可减少使用抗生素等药物引起的副作用。
【用法用量】使用时可直接将本品与其他饵料混合投喂,或稀释后全池定点或均匀泼洒。
1、用作海参、贝类、虾蟹类、鱼类及海胆育苗期开口饵料,配合常规饵料使用,建议用量1%或每日10g/m3水体。
2、用于亲本培育以及海参保苗、养成,配合常规饵料,建议用量0.5%或每日10g/m3水体。
3、对于轮虫孵化、土池育苗等用户亦可根据养殖实际情况酌情增减本品的使用量。
4、对虾养殖中按0.5%混合投喂。
【适用范围】:
1、海参、鲍鱼、贝类、对虾、鱼、海胆、蟹等工厂化育苗及扇贝的培养。
2、用于对虾、海参保苗期和养成期饲料添加剂。
3、轮虫养殖及营养强化。
【注意事项】本品禁止与杀菌剂,抗生素等混合使用。
【储存条件】阴凉干燥处保存。
【包装规格】500g/袋
【保 质 期】18个月。






Характеристики
Происхождение:
Вэйфан, Шаньдун, Китай
Ли импортировать:
Нет
Модель:
HYH1000
Пункт Нет.:
00028
Марка:
Биология Jiaqi
Эффективное содержание вещества:
100 миллиардов
Технические характеристики продукта:
1 кг мешок
Основное использование:
Аквакультура
КАС:
Ветеринарное бюро
Спецификация упаковки:
1 кг мешок
Наименование товара:
Морские красные дрожжи
Номер лицензии на производство кормовых добавок:
Лу Ситянь (2017)H07344
Номер утверждения корма/номер регистрационного свидетельства:
Лу Ситянь (2017)H07344
О продавце
Имя:
Оценка сервиса:
4.0
Оценка логистики:
3.2
Оценка споров и жалоб:
5.0
Оценка предложения:
3.6
Оценка консультации:
2.0
repeatPurchasePercent:
0.0
afterSalesExperienceScore:
3.6

Производители Оптовые морские дрожжи Дрожжи пивные дрожжи кормовые добавки дрожжи
437.40 ₽
437.40 ₽